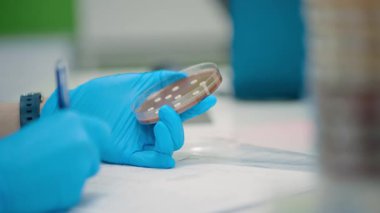
Bir laboratuar teknisyeni, bir petri kabını inceler ve modern laboratuvar uygulamalarını iş başında gösteren notlar alır.

En Çok Aranan Kelimeler
donanımkorumaprosedürteknolojiEldivenlerKlinikçalışmaVeriprofesyonelTest etYazılıyorHijyenkoruyucuörnekDeneyLaboratuvarBilimGüvenliNotlarkesinlikraporAraçlarGenel BakışRutinaraştırmaçalışma alanıanalizSonuçlarBilimselBelgelerİzleniyorDikkat etMikrobiyolojidenetlemegörevönlemAraştırmacıörneklerBelgelendirmetest ediliyoriletişim kuralıBenzer İçerikler